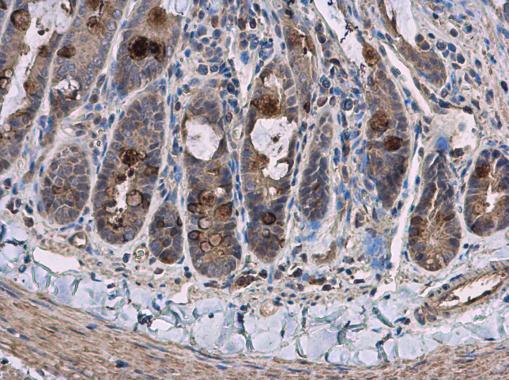
pyruvate carboxylase抗体

pyruvate carboxylase

pyruvate carboxylase (e6s3a) rabbit monocloning antibody
图片尺寸899x900
pyruvatecarboxylasepolyclonalantibody
图片尺寸659x903
【youtube】美式卡车 彼得比尔特 | 700 hp cummin
图片尺寸1152x720
pyruvate carboxylase抗体
图片尺寸509x380
pyruvate carboxylase antibody
图片尺寸650x330
cascadia2020款福莱纳卡斯卡迪亚freightlinercascadia卡车官方录影带
图片尺寸1728x1080
feedback-resistant pyruvate carboxylase gene from
图片尺寸2006x2944
feedback-resistant pyruvate carboxylase gene from
图片尺寸1792x3059
彼得比尔特peterbilt,重型卡车里的劳斯莱斯
图片尺寸750x500
新浪汽车
图片尺寸2048x1152
【转】彼得比尔特重型卡车工厂-peterbilt truck plant
图片尺寸1350x843
what does the regulation cycle of acetyl-coa carboxylase look
图片尺寸500x481
carboxylase
图片尺寸604x400
antipyruvatecarboxylaseantibody
图片尺寸210x145
pyruvate carboxylase-in-1结构式
图片尺寸600x600
素材-science slide fatty acids synthesis acetyl coa carboxylase
图片尺寸1080x810
雪弗兰chevroletc10pickuptruck1965
图片尺寸1080x720
羧化酶/加氧酶(ribulose-1,5-bisphosphate carboxylase/oxygenase
图片尺寸464x464
id="6229079">乙酰辅酶 /a>a羧化酶(acetyl coa carboxylase)是一种 a
图片尺寸482x321
molnutrfoodres封面综述膳食多酚靶向ampk信号通路来预防癌症
图片尺寸1080x775